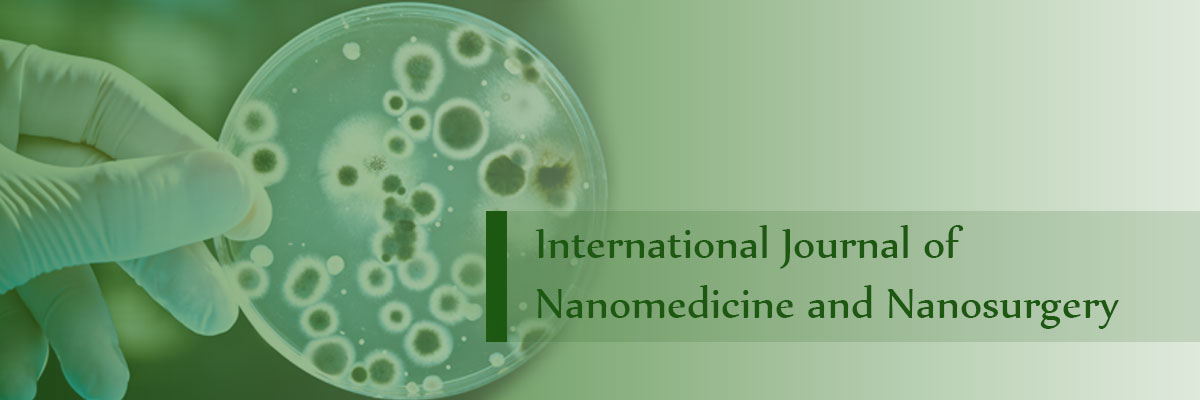

马可Agostini
研究科学家
肿瘤和外科科学系
帕多瓦大学,意大利帕多瓦
电话:0039-049-8214374
电子邮件:m.agostini@unipd.it
教育:
“狗屁” |
意大利帕多瓦大学(生物科学) |
博士学位。 |
意大利帕多瓦大学(肿瘤和外科科学) |

研究科学家
肿瘤和外科科学系
帕多瓦大学,意大利帕多瓦
电话:0039-049-8214374
电子邮件:m.agostini@unipd.it